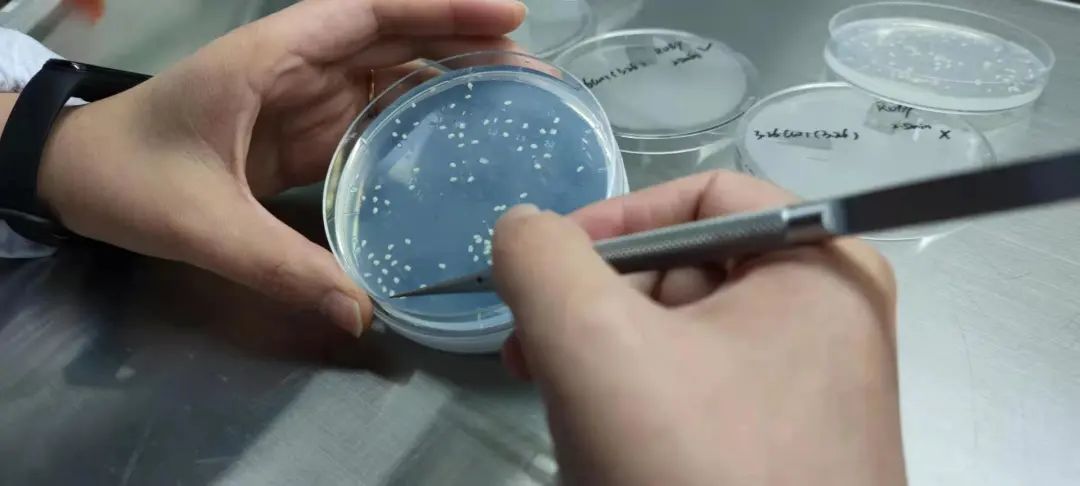

专注基因编辑育种,「艾迪晶生物」完成数千万元天使轮融资丨早起看早期

封面来源|视觉中国
36氪获悉,基因编辑育种公司「艾迪晶生物」宣布获得数千万元天使轮融资,本轮融资由济峰资本领投,涌铧投资跟投,取势资本担任长期独家财务顾问。根据创始团队透露,此轮融资将主要用于核心研发的继续投入、产品管线的深度布局以及现有成熟品种的商业化推广。
艾迪晶生物创始人兼总经理凌永国近期接受了36氪采访,介绍了基因编辑育种的市场规模和技术进展,以及艾迪晶生物的发展现状和未来规划。

育种是通过创造遗传变异、改良遗传特性,以培育动植物新品种,经历了从自然驯化、杂交和诱变育种发展到现代的生物技术育种。农作物育种的主要目标可以分成三个方面:
一是针对生物类胁迫,如致病微生物、害虫、寄生杂草等,培育能够抵抗抗病虫害的品种;二是针对非生物类的环境胁迫,如干旱、高盐碱、除草剂等,培育胁迫耐受、适应特定环境或抗除草剂的品种;三是针对生产和市场需求,培育具有优良性状的品种,如优质高产、抗倒伏、抗炸荚。
艾迪晶生物的核心技术源自刘耀光院士团队,该团队多年来一直从事生物技术研发和生物育种工作。“研发团队由院士领衔,国家杰青、国务院特殊津贴专家、副研究员等科研工作者构成,研发人员占全公司团队的25%,”凌永国告诉36氪,“研发团队基本上都在生物育种行业有十年左右的工作经验。”此外,凌永国曾在2011年与合伙人创立过一家生物技术公司,是生物技术领域的连续创业者。
艾迪晶生物目前拥有基因库+检测分析平台、基因编辑平台、分子生物学平台、高通量遗传转化平台和田间试验基地。据介绍,艾迪晶生物2021年入选国家高新技术企业,目前申请及授权发明专利、实用新型专利及软件著作权等25项。
在基因库+检测分析平台中,艾迪晶生物积累了大量的基因数据和品种数据,如基因组、转录组等数据以及国家种质资源的谱系信息,构建了专有数据库。凌永国举例介绍,“目前艾迪晶生物已拥有水稻基因一千多个,玉米功效基因有五六百个。”
此外,艾迪晶有专门的生物信息团队,针对基因编辑突变序列的分析开发了创新检测流程和检测软件,如基于Sanger测序的DSDecodeMI和基于二代测序的HiDecode。“DeDecode方法简单且便捷,HiDecode是一种混合建库的高通量方法,成本很低。这些软件和方法都易于操作,方便实验员快速上手。”
艾迪晶生物的基因编辑平台侧重工具开发和效率提升。“底层工具酶的开发已进入实质性阶段,预计明年可以拿出自己的专利酶。”据介绍,艾迪晶的多基因编辑系统能够实现30-40个基因的同时编辑。改进的单碱基编辑系统,如ABE、CBE和PE系统,编辑效率可以达到60%-70%。此外,凌永国补充道:“艾迪晶是国内最早做先导编辑的团队,在产品开发应用中2021年已经将效率提高到了40%。”
分子生物学平台和遗传转化平台是艾迪晶生物产业化应用的通路。艾迪晶生物官网提供了包括精准基因编辑、表达载体构建、蛋白质亚细胞定位、酵母双杂交和免疫共沉淀在内的技术服务内容。遗传转化平台“涉及的主要物种有20多个,如主粮作物中的水稻、玉米以及大豆、番茄和烟草等,可以不受品种和基因型的限制进行基因编辑。”
艾迪晶生物能够实现基因转化作物培育全阶段的严格环境控制,针对不同品种设计优化的培养方案和操作流程对转化效率、成功率都有提升。凌永国告36氪:“艾迪晶生物的遗传转化服务订单量已经达到了2万多个。”例如,艾迪晶生物与中国科学院西双版纳热带植物园及华中师范大学合作,利用改进的PE基因编辑技术成功创制了抗除草剂的新品种。
此外,艾迪晶生物已在湖北鄂州、海南三亚、云南西双版纳等地建立了标准化的种苗种植基地。田间试验基地的建立也为艾迪晶自营种业公司的商业模式提供了基础。据介绍,未来艾迪晶生物也将通过产权转让、许可分成、合作开发、渠道嫁接等方式推进产业化进程。


当前,艾迪晶生物的收入主要来自两个板块:技术服务和种业销售。技术服务板块凭借平台技术为种业公司、育种单位提供种业合同研究服务(CRO),包括品种改良、材料创制服务。此外,还与高校和研究院所合作开展功能基因研究;种业销售板块通过自营种业公司进行传统种业销售,如水稻、小麦、高粱、大麦的常规品种或杂交品种的销售。未来,在拿到基因编辑新品种的安全证书后,也将开展基因编辑品种的销售。
在技术服务方面,凌永国认为“行业竞争优势体现在基因编辑工具的精准性和高效性、可开发品种的广泛性以及项目交付的时效性中”。凌永国向36氪介绍了一个技术服务案例:艾迪晶生物曾给某种业公司的优势水稻品种提供口感提升、香味提升、粒型优化、降株高、抗除草剂五个方面的性状优化服务,在3-4个月的时间产出1000株苗,一次性筛选出多株含有8个基因同时发生纯合突变的材料。
艾迪晶生物的技术服务具备时间和成本优势,“如果没有高效的基因编辑工具,至少要花两年的时间才能得到这一结果。”在上述案例中,如果艾迪晶生物开发的新品种双方共享,商业化过程也与服务客户共同推进,收费标准约在20万元左右,“如果仅提供服务、不含合作开发,收入至少50万元量级。”

对于国内外生物育种发展的差异,凌永国表示:“政策方面,中国的基因编辑育种在今年开始放开,国外部分国家如美国、日本等已经形成了商业化的政策闭环;核心技术层面,中国的基因编辑工作酶相对比较稀缺,主要专利掌握在美国等国家手中;产品方面,国外的基因编辑西红柿、大豆甚至基因编辑猪已经上市,中国目前还没有相关产品;当然,我国在多基因编辑等技术方面也处于世界领先水平。”
根据这些差异,艾迪晶生物的未来发展布局将围绕四个方面展开:一是高效基因编辑工具酶的开发,二是精准基因编辑技术和多基因编辑技术的升级和优化,三是关键基因位点的挖掘,四是产出真正解决市场需求痛点的优秀品种。
36氪了解到,生物育种行业的政策利好正不断涌现。21年7月,中央下发了《种业振兴行动方案》,强调大力推进种业创新攻关,实施生物育种重大项目,有序推进产业化应用。21年12月印发的《“十四五”全国生物经济发展规划》中提到要发展种质资源创新和现代生物育种技术。22年1月,中国农业农村部为规范农业用基因编辑植物安全性评价工作,制定了《农业用基因编辑植物安全评价指南(试行)》,2022年又被业界称为“中国生物育种元年”。
英国知名咨询公司IDTechEX预测,到2031年,全球农作物生物技术的市场规模将达到443亿美元。“中国的主粮作物市场规模在1300亿元左右,玉米每年销售额达到400多亿元,水稻每年将近300亿元”凌永国告诉36氪,“若能通过基因编辑开发出真正解决市场需求痛点的优质品种,就玉米来说,实现10%的替代就有40亿的市场。从目前的政策和市场导向来看,未来的替代率会达到80%到90%。”
36氪了解到,生物育种巨头拜尔作物科学(原孟山都)2022H1的营收(EBITDA before special items)达到了54.18亿欧元。CRISPR基因编辑技术的重要研发者之一张锋成立的初创公司Pairwise已累计融资1.15亿美元。